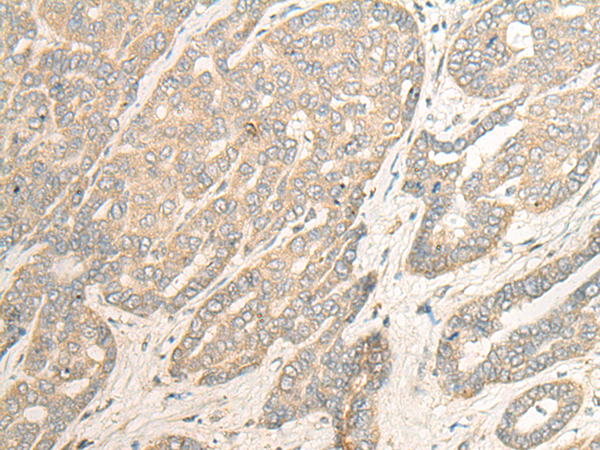

-
分类: 科研抗体货号: P09634别名: HEL-S-98n应用: WB,IHC反应种属: Human
-
分类: 科研抗体货号: P09616别名: DEM1; Exo V; hExo5; C1orf176应用: IHC反应种属: Human, Mouse
-
分类: 科研抗体货号: P09648别名:应用: WB,IHC反应种属: Human
-
分类: 科研抗体货号: P09632别名: VIB1B; PtdInsTP; PI-TP-beta应用: WB,IHC反应种属: Human, Mouse, Rat
-
分类: 科研抗体货号: P09615别名: SGD; DAGD; 35DAG; CMD1L; SGCDP; SG-delta应用: WB,IHC反应种属: Human, Mouse
-
分类: 科研抗体货号: P09647别名: CGI-25应用: IHC反应种属: Human, Mouse
-
分类: 科研抗体货号: P09631别名: ELA3; ELA3A应用: IHC反应种属: Human
-
分类: 科研抗体货号: P09614别名: ADL; DAG2; 50DAG; DMDA2; LGMD2D; SCARMD1; adhalin应用: IHC反应种属: Human, Mouse
-
分类: 科研抗体货号: P09646别名: HLALS应用: IHC反应种属: Human
-
分类: 科研抗体货号: P09630别名: TSK3; SPOGA3; STK22C; STK22D应用: IHC反应种属: Human, Mouse

鄂公网安备42018502007531号
鄂公网安备42018502007531号

